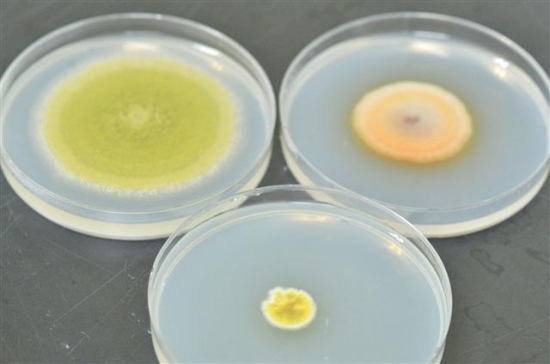

순창군, 한국형 미생물균 발견…고부가가치 창출 기대

순창군이 최근 순창지역에서 고부가가치를 창출할 수 있는 황국균(Aspegillus oryzae), 홍국균(Monascus ruber), 금화균(Eurotium sp)등을 발견했다고 밝혔다.
17일 군 장류사업소에 따르면 현재 국내 장류·주류 제조에 사용되고 있는 미생물은 대부분 일본산 종균으로 전통식품의 정체성에 많은 문제를 안고 있어 한국형 토종 미생물의 자원화에 대한 국가적 관심이 집중되고 있는 상태다.
따라서 이번 순창군에서 분리한 황국균 등은 이런 의미에서 전통식품의 정체성 회복 뿐만 아니라 국내 산업발전에 큰 도움이 될 것으로 예상된다.
황국균은 일반적으로 메주를 발효하는 과정 중에 착생되는 곰팡이로, 고초균과 더불어 전통장류 발효에 중요한 역할을 하는 것으로 알려져 있다.
이번에 발견된 것은 혈행개선 효과와 산업화에 문제가 되는 곰팡이 독소를 생성하지 않아 향후 장류제품 개발에 크게 활용될 전망이다.
또한 홍국균은 인체 내에서 콜레스테롤의 합성 억제효과로 식품·제약 산업에서 활용 연구가 이루어지고 있는 균이다.
중국에서는 금화균이 핀 차가 고가에 판매되는 등 고부가가치 차로 알려져 있다.
순창군 장류사업소는 이번 연구를 통해 순창지역에서 생산된 메주 및 장류제품에서 다양한 곰팡이 등 67종을 분리했으며, 이중 유전자 분석과 다양한 실험을 통해 우수한 황국균, 홍국균, 금화균을 찾아냈다.
군 장류사업소 관계자는 "이번 분리된 균을 활용해 심 혈관 만성질환을 예방할 수 있는 제품을 개발할 예정"이라며 "앞으로도 꾸준한 미생물 자원화 연구와 고부가가치 제품 개발을 통해 발효 종주 도시인 순창의 위상을 더욱 높여 나가겠다"고 밝혔다.
순창=ing6531






 홈
홈

※ 아래 경우에는 고지 없이 삭제하겠습니다.
·음란 및 청소년 유해 정보 ·개인정보 ·명예훼손 소지가 있는 댓글 ·같은(또는 일부만 다르게 쓴) 글 2회 이상의 댓글 · 차별(비하)하는 단어를 사용하거나 내용의 댓글 ·기타 관련 법률 및 법령에 어긋나는 댓글
BEST 댓글
답글과 추천수를 합산하여 자동으로 노출됩니다.